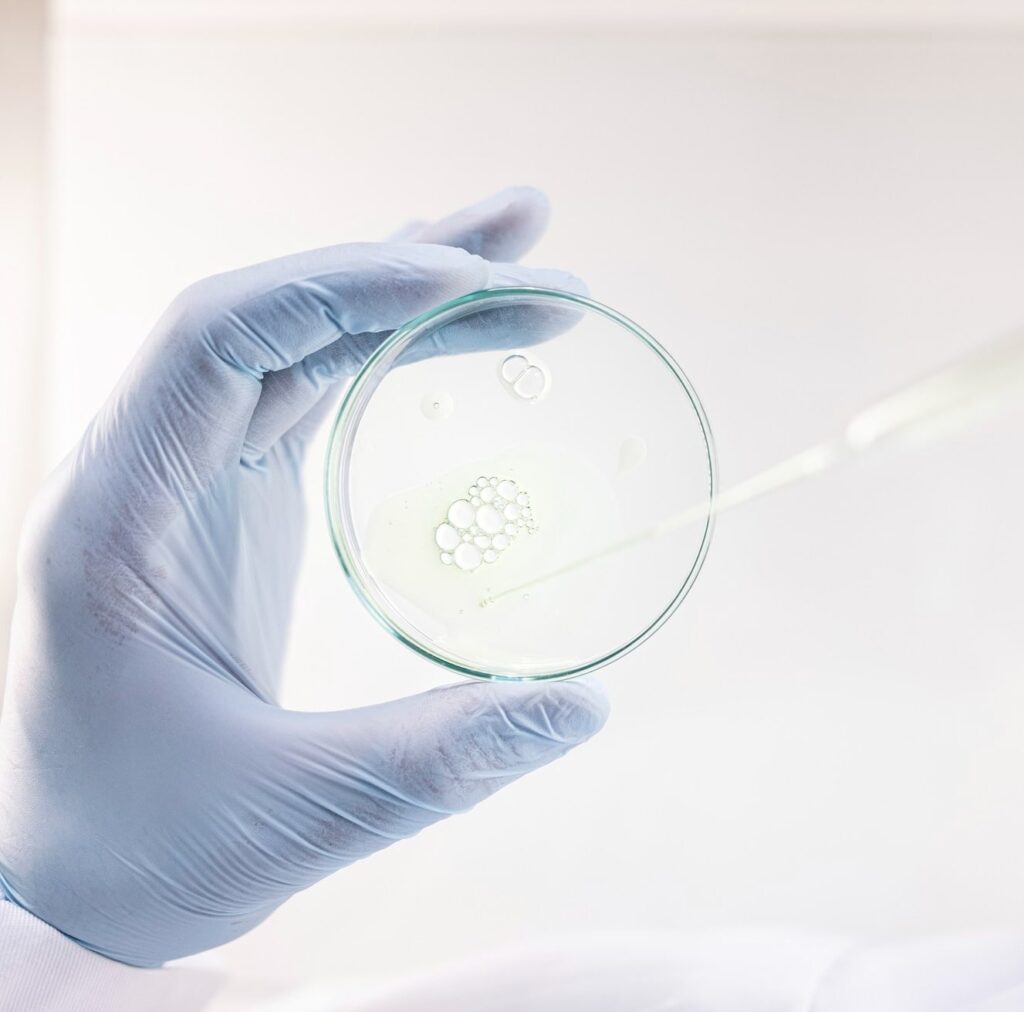

Tarım, biyoteknoloji ve araştırma alanlarında uzmanlaşma sağlanarak, bilimsel ve teknolojik gelişmelere uygun profesyonel çözümler sunulmaktadır.
Eğitim & Danışmanlık
Uluslararası standartlara uygun tarımsal üretim, araştırma, laboratuvar teknikleri ve biyoteknolojik uygulamalar konularında eğitim, danışmanlık ve kurs hizmetleri sunulmaktadır.
1. Akredite Tarımsal Araştırma Laboratuvarları & Merkezlerinin Kurulumu
Uluslararası akreditasyona uygun tarımsal araştırma laboratuvarları ve araştırma merkezlerinin planlanması ve kurulumu.
2. Etüt, Plan, Proje ve Fizibilite Hizmetleri & Eğitimleri
Tarımsal üretim veya araştırmaya yönelik etüt, plan, proje ve fizibilite çalışmalarının hazırlanması ve bu konularda eğitimler.
3. Bitkisel Üretime Yönelik Eğitimler
- Türe spesifik fide-fidan üretimi ve çoğaltma metotları
- Aşılama teknikleri ve uygulamaları
- Dikim ve terbiye şekilleri
- Budama yöntemleri
- Sürdürülebilir tarım teknikleri ve yetiştiricilik
- Bahçe bitkilerinin soğuk hava depolarında muhafaza yöntemleri
4. Moleküler Analiz Eğitimleri
- DNA, RNA & Protein İzolasyonu
- PCR, Real-Time PCR, dd-PCR uygulamaları
- RNA İnterferans Teknikleri
- Crispr/Cas9 Gen Düzenleme Teknolojisi
- Klonlama ve genetik mühendisliği uygulamaları